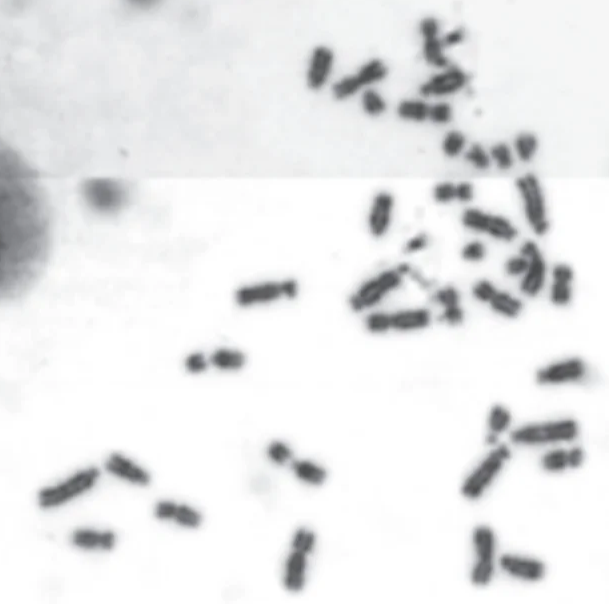
1755850101381

アジアには何種のモグラがいるのだろうか?

川田 伸一郎(かわだ しんいちろう)
動物研究部
脊椎動物研究グループ
モグラは日本ではよく知られた動物ですが、アジアの他の国では認知度が低い動物です。日本のように田畑を荒らす害獣というイメージはなく、森の地下でひっそりと暮らしている珍しい動物です。研究者の眼から見ても、歴史的にあまり研究がされておらず、何種に分類できるのかまだよくわかっていません。僕は自慢のモグラ捕りの技を使って、これらを捕まえて形態学的研究を行っています。
基本的には捕まえたモグラたちを毛皮と骨の標本にして、ヨーロッパや北米の博物館に保管されている古い標本と比較して種の同定をしていきます。ところがどうしてもうまく同定できないものが見つかってきました。こういった種に関しては形態の記載を行い、新しい名前をつけます。新種の哺乳類が今でも見つかっているなんて驚くかもしれませんが、これまでに台湾とベトナムで各 1種が新種記載されています。アジアのモグラの種数はまだまだ増えそうです。
まずは外部形態を観察して...
頭骨をしっかりと調べまして...
モグラは体の骨もとっても面白いんだよね...
染色体なんかも調べちゃいます。
これは僕がEuroscaptor subanuraと名付けたベトナムのモグラ。
染色体数は38本で、モグラ類ではこれまでに知られていない数でした。
研究員に聞いてみました!

1)専門は何ですか?
モグラの分類学です。でも、もっぱら標本作りばかりやってます。
2)研究者になろうと思ったきっかけは何ですか?
子どものころから昆虫が大好きで、生き物の研究がやりたいと思ってました。大学で哺乳類に目覚めました。
3)最近の研究活動で、最も興味深かった出来事は何ですか?
実は哺乳類の研究史も調べておりまして、明治時代の無名の採集人たちの活動と標本や論文の内容がパズルのようにはまっていくのに快感を感じてます。
4)研究者になりたい方に一言アドバイスを !
ブレイブを黙らせるな、いつもチャレンジャー。情熱を大切にしてください。